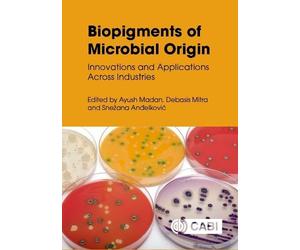
Biopigments of Microbial Origin: Innovations and Applications Across Industries

🤖 Demande à ChatGPT
applications of microbial - Comparez les prix parmi 8 offres disponibles chez nos partenaires et achetez moins cher.
Quel est le meilleur prix pour applications of microbial ?
Aujourd´hui, le 2026-03-08, Amazon.fr vous offre le meilleur prix. Vous pouvez y acheter applications of microbial pour 129,95 €. Les prix changent régulièrement. Comparez les prix en revenant plus tard.
Vous pourrez commander applications of microbial au meilleur prix chez Amazon.fr et bien d'autres.
Les meilleurs prix pour applications of microbial vous sont proposés par nos partenaires Amazon.fr, Rakuten.com FR et Fnac.com (Marketplace). Ces offres ont été sélectionnées spécialement pour vous parmi 3 e-magasins associés. Il y a des centaines de commercants en ligne qui sont référencés sur Prix.net, votre comparateur de prix ultra-rapide et efficcace.
Liste des marchands proposant la recherche applications of microbial:
- Amazon.fr
- Rakuten.com FR
- Fnac.com (Marketplace)
applications of microbial Amazon.fr
L'e-shop Amazon.fr vend applications of microbial. Ce shop fait parmi de nos partenaires parmi d'autres centaines de marchands sur le net.
applications of microbial est en vente en ligne et est proposé par plusieurs marques sur internet.
Une seule marque propose cette recherche ou cet article. Il s'agit de Nova Science Publishers.
Il n'y a pas de recherche similaire à cet requête. Choississez un autre produit le moteur de recherche de produit de prix.net si vous êtes intéressé par un produit ressemblant ou s'y raprochant.
Aucun renseignement concernant une couleur est indiqué ou renseigné par le marchand en ligne pour cette requête.
Comparer les prix avant tous achats en ligne
Pour tous vos achats sur la toile, ayez le réflexe d’utiliser prix.net, votre comparateur de prix rapide et efficace pour bénéficier des meilleures bonnes affaires en ligne. Quelque soit le thème de votre recherche avant un achat sur la toile, entrez le nom du produit ou de la catégorie de produit, nous vous montrerons les meilleures offres de nos partenaires marchands. Vous n’aurez alors plus qu’à décider le prix, le mode de paiement et les délais de livraison qui vous correspondent et vous pourrez finaliser votre achat directement chez le marchand en ligne.
Comment fonctionne notre comparateur de prix ?
Réaliser de bonnes affaires sur le net est simple et rapide grâce au comparateur de prix, prix.net. Nous analysons et proposons en temps réel les offres les plus intéressantes et pertinentes de nos partenaires. Nous faisons le travail de recherche pour vous. Entrez le nom du produit que vous souhaitez acheter en ligne, nous vous présenterons les meilleurs résultats et souvent au meilleur prix.